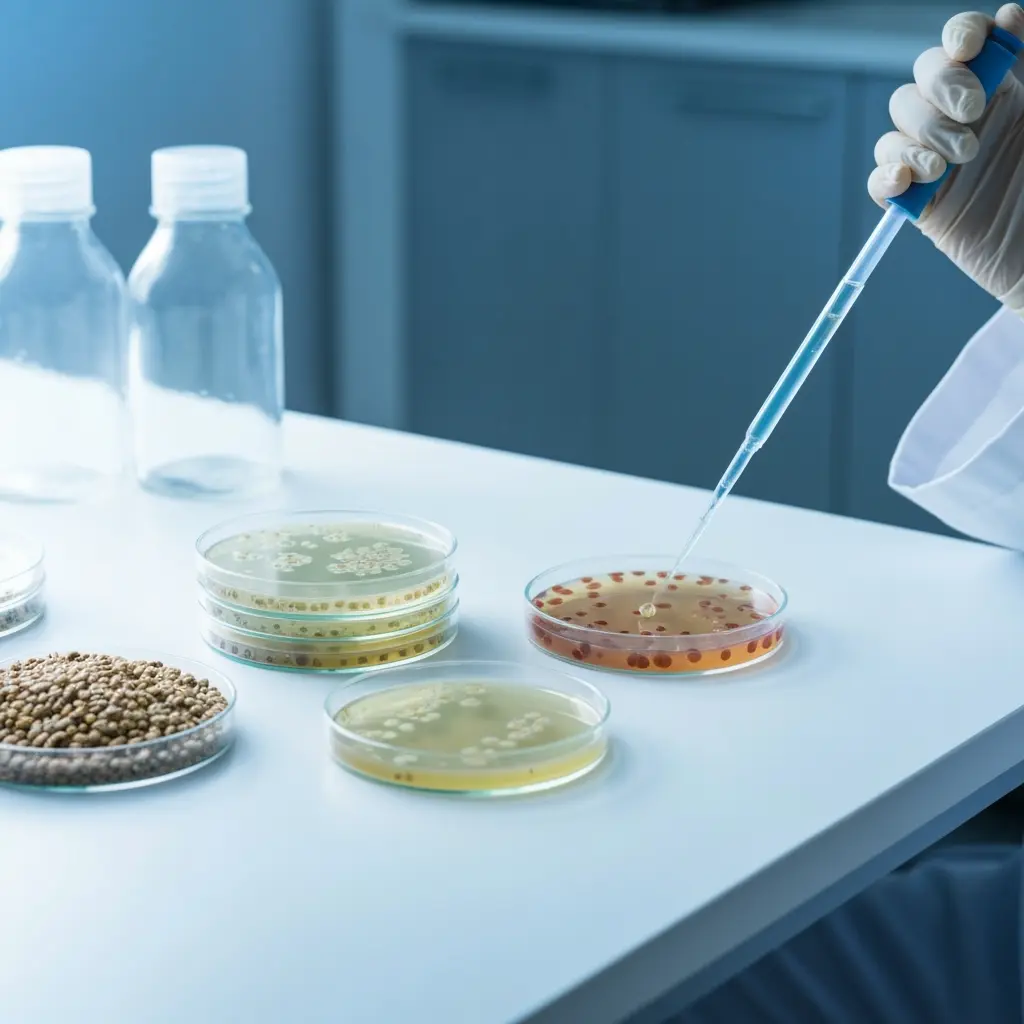

Comprehensive Animal Feed Testing for Quality and Safety
Our Testing Capabilities
Quality Nutrition for Healthy Livestock
Animal feed directly impacts livestock health, productivity, and ultimately food safety for human consumption. Poor-quality feed or contamination with toxins, pathogens, or heavy metals can lead to significant economic losses and health risks.
At Salalah Laboratories, we provide advanced testing solutions for animal feed to ensure nutritional adequacy, regulatory compliance, and safety. Our team uses precise methodologies to evaluate feed composition and detect contaminants, helping manufacturers, farmers, and suppliers maintain the highest quality standards.
We provide a wide range of Animal Feed testing services
Our Testing Capabilities
Tests
Nutritional & Chemical Analysis
Moisture, Protein, Fat, Fiber, and Ash Content
Carbohydrates and Energy Value
Major Minerals and Trace Elements (Ca, Mg, Na, K, P, Fe & Zn, etc…)


Tests
Contaminant Testing
Mycotoxins (Aflatoxins, Ochratoxins, DON, Zearalenone etc .)
Pesticide Residues
Heavy Metals and Trace Metals (As, Cd, Pb,& Hg etc….)
Unapproved Additives or Preservatives
Tests
Microbiological Testing
Salmonella and other harmful pathogens
Yeast & Mould counts
Hygiene indicator organisms

Tests
Specialized Tests
Vitamins and Micronutrients
Fatty Acid Profile including Omega-3 and Trans Fats
Total Sugars & Added Sugar content (for certain feed formulations)
Additional Services
01
Environmental Monitoring
Using swab samples, contact plates, or settle plates to check hygiene in facilities.
02
Hand Swabs
Detecting Staphylococcus aureus and E. coli on food handlers.





Industries We Support
Dairy & Poultry Farms
Ensuring feed quality for milk and egg production.
Aquaculture & Fisheries
Testing fish feed to prevent contamination and nutrient imbalance.
Meat & Livestock Producers
Protecting animal health and growth.
Feed Manufacturers & Distributors
Validating formulations and compliance with export standards.
Comprehensive Medical Services
Why ChooseSalalah Laboratories
-
1
Accreditation
ISO/IEC 17025:2017 accredited by GCC Accreditation Center -
2
Modern lab
Modern laboratory instruments and validated testing methods -
3
Local expertise
Local expertise combined with internationally recognised standards

Client Experiences
Trusted by
Leading Brands and Businesses
Salalah Labs’ microbiological testing gave us clear, detailed results that helped us pass a key export inspection. Their professionalism and speed made all the difference.
Aisha
Food Manufacturer
We needed urgent water testing for a government tender. Salalah Labs delivered accurate results within days, ensuring we met all compliance requirements
Fahad
Water Treatment Company
Their nutritional analysis reports are thorough and easy to understand, which helps us market our products with confidence.
Samar
Snack Brand Owner
Animal feed testing from Salalah Labs has been a game-changer for our quality control. They are consistent, transparent, and highly skilled.
Hasan
Feed Mill Owner
Frequently Asked Questions

Your Guide to
Common Questions
Learn more about who we are, how we work, and what makes our laboratory a trusted partner for businesses across Oman and the GCC.
How do I submit samples for testing?
You can deliver samples directly to our laboratory in Salalah or arrange for courier pickup. Our team will guide you on the correct sample quantity, packaging, and storage requirements.
How long does testing usually take?
Turnaround time depends on the type of test. Standard analyses are typically completed within a few working days, while specialized tests may require additional time.
Are your results accepted by regulators and international buyers?
Yes. Our laboratory is ISO/IEC 17025:2017 accredited by the GCC Accreditation Center, meaning our reports are internationally recognised and trusted.
Do you provide consultation on which tests are needed?
Yes. Our experts will help you identify the right testing methods based on your product type, compliance needs, and market requirements.
